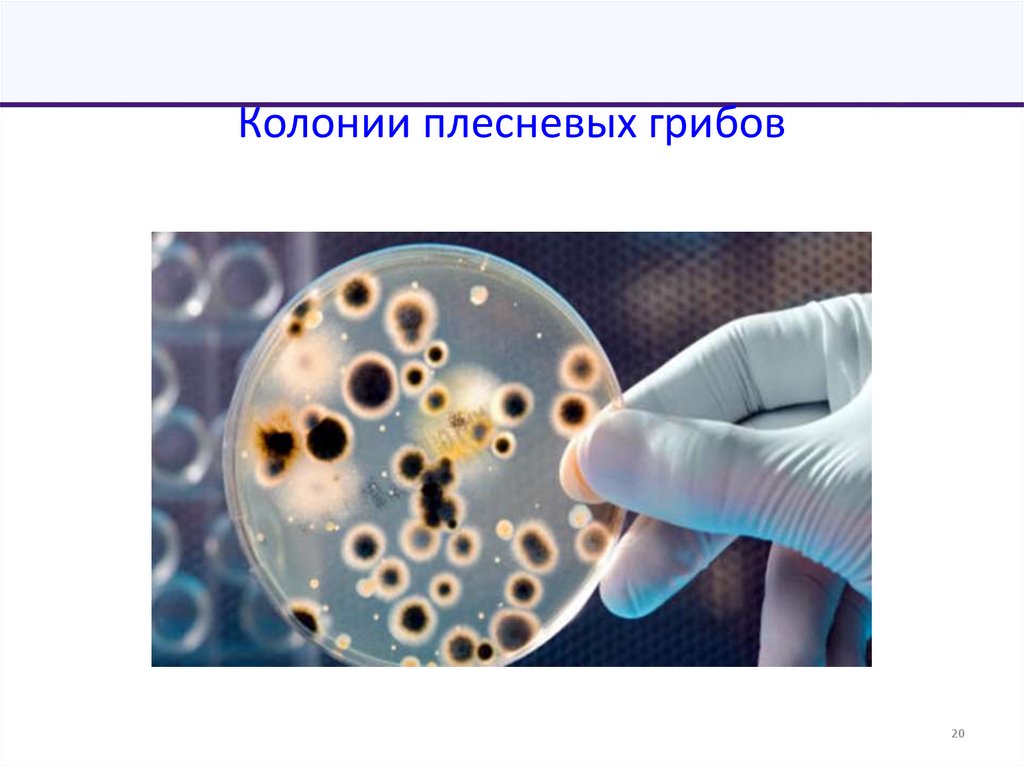
Колонии плесневых грибов
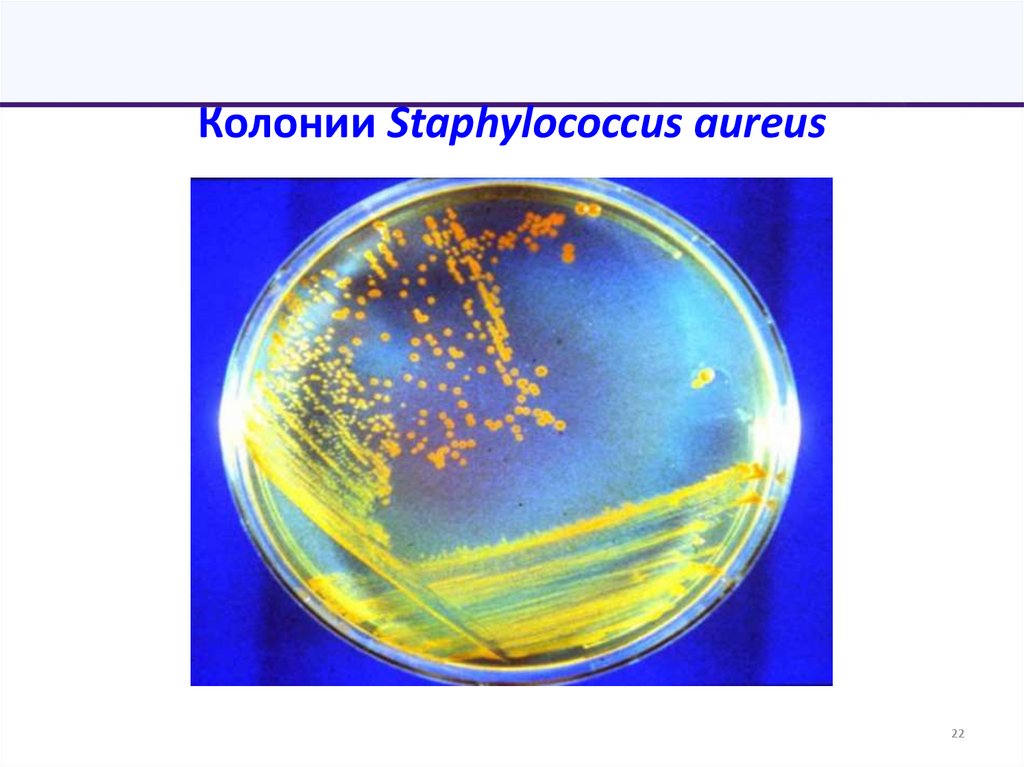
Колонии Staphylococcus aureus

Похожие презентации:
Предмет и задачи медицинской микробиологии. Классификация и морфология микроорганизмов
1. Федеральное государственное бюджетное образовательное учреждение высшего образования «Ульяновский государственный университет»
Лектор: Потатуркина-Нестерова Наталия Иосифовнадоктор медицинских наук, профессор
зав. курсом микробиологии
кафедры общей и клинической фармакологии с курсом микробиологии
1
2. Медицинская микробиология, вирусология
II cеместр:- 9 лекций
- 9 практических занятий
- Зачет (июнь 2026 г.)
III семестр:
- 9 лекций,
- 9 практических занятий
- Экзамен (январь 2027г.)
Практические занятия:
пр. врача Сурова, №4, корпус детского стационара
ГУЗ «Детская городская клиническая больница
города Ульяновска»
2
3.
Лекция 1.«Предмет и задачи
медицинской микробиологии.
Классификация и морфология
микроорганизмов»
3
4. План лекции
1. Предмет микробиологии. История2. Задачи медицинской микробиологии
3. Систематика и номенклатура м/о
4. Методы микробиологии
5. Виды микроскопии. Техника приготовления мазков
6. Морфология и химический состав бактерий
7. Стерилизация, дезинфекция
4
5. Микробиология (micros, bios)
• это наука, изучающая микроорганизмы, т.е. организмы,невидимые невооружённым взглядом
Микробиология подразделяется на виды:
• медицинская
• ветеринарная
• сельскохозяйственная
• техническая (биотехнология)
• космическая и др.
5
6. Медицинская микробиология
• Изучает возбудителей заболеваний человекаРазделы медицинской микробиологии
Бактериология
Вирусология
Микология
Протозоология
Микология
Санитарная микробиология
Клиническая микробиология
6
7. Задачи медицинской микробиологии
1. Определение этиологической роли микроорганизмов внорме и патологии.
2. Разработка методов микробиологической диагностики
и специфической профилактики.
3. Контроль окружающей среды, за источниками
инфекции в лечебных и детских учреждениях,
продуктов питания, соблюдения режима стерилизации.
4. Контроль за чувствительностью микроорганизмов к
антибиотикам, состоянием микробиоценозов организма
человека.
7
8. История микробиологии
Периоды развития• Эвристический
• Морфологический
• Физиологический
• Иммунологический
• Молекулярно-генетический
8
9. Эвристический период
• Эвристика – догадка• До изобретения микроскопов и их
использования для изучения микромира
• III-IV в.в. до н.э. Гиппократ – болезни,
передающиеся от человека к человеку
вызываются невидимыми веществами,
образующимися в гнилых болотах
• ХV-ХVI в.в. итальянский врач
Фракасторо – болезни вызываются
«живыми контагиями»
9
10. Морфологический период
• Конец XVII – сер. XIX в.• Открытие мира микроорганизмов,
описание их внешнего вида
• Микроскоп Левенгука
• Антони ван Левенгук –
в 1675г. впервые описал
простейших, в 1683г.основные формы бактерий.
Создание микроскопов
(максимальное ув.х300)
10
11. Физиологический период
• Середина XIX – начало ХХ в.• Открытие болезнетворных бактерий, изучение жизнедеятельности
микробной клетки, начало научной микробиологии
Луи Пастер (1822-1895) - основы процессов брожения,
развитие промышленной микробиологии, роль
микроорганизмов в кругообороте веществ в
природе, открытие анаэробных микроорганизмов,
разработка принципов аттенуации вирулентности
и получения вакцин
Роберт Кох (1843-1910) - разработал метод
выделения чистых культур, способы окраски бактерий,
открыл возбудителей сибирской язвы,холеры,
туберкулеза, усовершенствовал технику микроскопии,
11
12. Открытие антибиотиков
• В 1929г. А. Флеминг открыл пенициллини началась эра антибиотикотерапии,
приведшая к революционному прогрессу
медицины
• В дальнейшем выяснилось, что микробы
приспосабливаются к антибиотикам
• Изучение механизмов лекарственной устойчивости
12
13. Иммунологический период
• Начало – середина ХХ в.• Открытие иммунитета
• Мечников - создал клеточную теорию
фагоцитоза
• Одновременно накапливались данные
о выработке в организме антител против
токсинов, позволившие П. Эрлиху
разработать гуморальную теорию
иммунитета
• Открытие структуры антител
Илья Ильич Мечников
(1845-1916)
13
14. Молекулярно-генетический период
• С середины ХХ в., связан с достижениями генетики имолекулярной биологии, созданием электронного микроскопа
• Изучение генной структуры микроорганизмов
• Определение генетических детерминант патогенности
микроорганизмов
• Стало возможным конструирование и пересадка генов. Создана
биотехнология
• Расшифрованы молекулярно-генетическая организация многих
вирусов и механизмы их взаимодействия с клетками
• Молекулярно-генетические методы исследования (ПЦР и др.)
14
15. Систематика микроорганизмов
• Таксономия (греч. taxis - расположение по порядку, закон) - этораздел систематики, изучающий принципы и методы
классификации организмов в иерархическом порядке.
• Таксон - группы микроорганизмов с однородными свойствами.
• Классификация - распределение микроорганизмов в
соответствии с их общими свойствами по различным таксонам.
• Идентификация (лат. identifico - отождествление) установление принадлежности изучаемого организма к тому или
иному таксону, определение вида.
15
16. Таксономическая иерархия микроорганизмов
ДоменНадцарство
Царство
Подцарство
Класс
Отдел
Порядок
Семейство
Род
Вид:
биовары,
серовары,
фаговары и т.д.
• Вид- это совокупность
особей, объединенных
эволюционно
сложившимися
близкими свойствами,
но отличающихся от
других представителей
рода
16
17. Микробиология изучает:
• надцарство безъядерных – Akaryota (karyon-ядро,греч.) - вирусы, вироиды, прионы;
• надцарство предъядерных – Prokaryota (pro- пред,
греч.) - бактерии, имеющие ядерный материал в
виде одной хромосомы в одной клетке, являющейся
целым организмом;
• надцарство ядерных – Eukaryota (еu- настоящий)
- микроскопические грибы, простейшие.
17
18. Систематика микроорганизмов
1819. Номенклатура микроорганизмов
Микроорганизмы обозначают всоответствии с международными
правилами.
• Бинарная номенклатура
• Пример:
Род
вид
Escherichia coli
• Термины: чистая культура, штамм, клон,
колония, вариант (Var) – биовар, хемовар,
фаговар
19
20. Колонии плесневых грибов
2021. Разнообразие колоний
2122. Колонии Staphylococcus aureus
2223. Методы микробиологии
• Микроскопический• Культурально-биохимический – выделение чистой
культуры возбудителя, изучение ее свойств, в том числе
биохимических, и по совокупности этих свойств
определение вида выделенной культуры
• Серологический – выявление антител в сыворотке крови
• Биологический – воспроизведение инфекционного
заболевания у животных
• Аллергический – выявление повышенной
чувствительности к возбудителю
• Молекулярно-генетический – выявление генетического
материала возбудителя
23
24. Микроскопический метод
Изучение микроорганизмов при помощи микроскопаПозволяют определить форму, размеры, взаимное
расположение микроорганизмов, внутреннюю структуру
Различают следующие виды микроскопическии
1) световые:
• иммерсионная
• люминесцентный
• фазово-контрастная
• темнопольная
2) электронная
3) атомно-силовая
24
25. Микроскопический метод
2526.
2627. Работа с культурой бактерий
2728. Простые и сложные методы окраски
• Простые методы – один краситель (фуксин, метиленоваясинь). Выявляет размер, форму и взаимное расположение.
• Сложные методы - помимо этого позволяют выявить
отдельные структуры. По Граму, Цилю-Нильсену, Нейссеру
и др.
28
29.
2930. Грамположительные (слева) и грамотрицательные (справа) бактерии
Разрешающая способностьиммерсионного микроскопа
находится в пределах 0,2 мкм, а
максимальное увеличение объекта
достигает 1350-1350.
30
31. Иммерсионная микроскопия (лат. immersio – погружение) Ув. х90 (х100), а в сочетании с окуляром х10 (х15) получается увеличение
в 900 (1000-1500) раз.Разрешающая способность: 0,1мкм
31
32. Люминесцентная микроскопия
Используют ультрафиолетовые лучи.Метод микроскопии, позволяющий наблюдать
первичную или вторичную (флюорохромы)
люминесценцию микроорганизмов. Под действием
ультрафиолетовых лучей наблюдается свечение
объекта
32
33. Фазово–контрастная микроскопия
Увеличивает контрастность изображения прозрачныхобъектов.
Световые волны, проходя через оптически более плотные
участки объекта, отстают по фазе от световых волн, что не
улавливаеся глазом.
Далее фазовые колебания при помощи специальной
оптической системы превращаются в амплитудные, хорошо
улавливаемые глазом. Препараты в световом поле зрения
становятся более контрастными.
33
34. Темнопольная микроскопия
Проводится при боковом освещении с применением специальногопараболоид–конденсора, в котором центральная часть затемнена, а боковая
поверхность зеркальная. Этот конденсор задерживает центральную часть
пучка лучей, образуя темное поле зрения.
Краевые лучи проходят через кольцевую щель, попадают на боковую
зеркальную поверхность конденсора, отражаются от нее и концентрируются в
его фокусе.
Когда луч встречает на своем пути микробы, свет отражается от них и попадает
в объектив – клетки ярко светятся.
Применяется для исследования прозрачных живых объектов.
34
35. Электронная микроскопия
3536. Атомно-силовая микроскопия
• Используется сканирующийзондовый микроскоп для
изучения морфологических
и упруго-эластических
свойств бактерий.
Кантилевер «обстукивает»
поверхность объекта.
36
37. АСМ - изображение B.subtilis (3D)
3738. Цифровая микроскопия
3839. Виды микробиологических лабораторий
По объекту изучения• Бактериологические (по степени опасности)
• Вирусологические (по степени опасности)
• Микологические
• Иммунологические
По цели работы
Лечебно-диагностические
Учебные
Научно-исследовательские
Специализированные (особо опасные)
Санитарно-бактериологические
39
40. Формы бактерий
• Кокки (сферические): моно-, дипло-, стрепто-, стафило-,сарцины.
• Бактерии (палочковидные): правильной формы,
ветвящиеся, бациллы, клостридии
• Извитые формы:
- слегка изогнутые (в виде запятой)– вибрионы
- спириллы – спиралевидные (неподвижные)
- спирохеты - спиралевидные (подвижные)
40
41. Сарцины
4142. Диплококки
4243. Стрептококки
4344. Палочковидные и извитые формы бактерий
4445. Структура бактериальной клетки
4546. ОБОЛОЧКА: клеточная стенка (защита и форма) +циплазматическая мембрана (пермиазы-транспорт веществ, регуляция энергетического
обмена,осмотического давления)
46
47. Бактерии с измененной клеточной стенкой
• Протопласты –лишены оболочки• Сферопласты – частично лишены оболочки
• L-формы – прото- и сферопласты, способные размножаться. Часто под
действием антибиотиков.
От названия института Листера, где их впервые описали.
Способны реверсировать,
вызывать заболевания.
Не чувствительны к
антибиотикам, антителам,
многим химиопрепаратам
47
48. Цитоплазма
• Содержит растворимые белки, РНКвключения, рибосомы.• Рибосомы имеют коэффициент седиментации 70S в отличие от
рибосом эукаритических клеток (80S). Поэтому многие
антибиотики подавляют синтез бактериального белка, не влияя
на синтез белка эукариотических клеток.
• В состав 30S входит 16S рРНК, изучение которой является
основой геносистематики бактерий при определении родства
микроорганизмов.
48
49. Нуклеоид
4950. Капсула, микрокапсула
• Капсула – полисахариды, препятствует фагоцитозу,гидрофильна, антигенна. Выявление – метод Бурри-Гинса.
• Микрокапсула – мукоидные
экзополисахариды. Защита
от высыхания, от бактериофагов, повреждений.
50
51. Жгутики
• Определяют подвижность• Состоят из сократительного белка флагеллина,
являющегося антигеном.
• Состоят из 3-х частей: нити, крюка и базального тельца,
прикрепленного к цитоплазматической мембране и
клеточной стенке. Базальное тельце содержит диски.
• Жгутики выявляют прямыми или косвенными методами.
• Прямые – адсорбируют на жгутиках некоторые вещества
(напр., танин), после чего увеличиваются толщина
жгутиков.
• Косвенные – методы висящей и раздавленной капли по
наличию движения бактерий.
51
52. Расположение жгутиков
монотрихальнолофотрихально
амфитрихально
лоботрихально
перитрихально
53. Жгутики и пили
54. Ворсинки (pili)
• Состоят из белка пилина• Отходят от поверхности клетки
• Обладают антигенной активностью
• Функции и виды фимбрий:
1) адгезия к поражаемой клетке;
2) участие в обмене веществ (common pili)
3) F-пили – (F-фертильность) конъюгационные или
половые, участие в передаче генетической
информации.
54
55.
5556.
5657. Стерилизация (sterilis-бесплодный)
• Это полное уничтожение микробовМетоды стерилизации:
• тепловой - действием высокой температуры (денатурация
белка, деградация нуклеиновых кислот, липидов,
• лучевой,
• химический - токсичными газами, растворами,
• лучевая,
• лазерный,
• микроволновый,
• плазменный,
• фильтрование,
• при помощи озона.
57
58. Автоклав. Сухожаровой шкаф
5859. Дезинфекция
• это уничтожение большей части микробов (оставшиеся немогут вызвать заболевание)
Методы дезинфекции:
• тепловой (80-90 градусов, например, пастеризация),
химический - дез. веществами,
• УФ-облучение и др.
59

Медицина
Медицина








